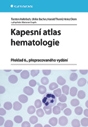
Kapesní atlas hematologie

Zde najdete přehled knih s onkologickou tematikou, které byly publikovány od roku 1994 v České republice nebo v zahraničí našimi autory. Knížky si můžete zobrazit podle autorů, roku vydání nebo podle klíčových slov (štítků). Můžete také jednoduše vložit autora nebo část názvu knihy.
Přehled neobsahuje informační brožury určené pacientům, ty můžete najít v databázi brožur, včetně plného textu ke stažení, v části Linkos pro pacienty a jejich blízké.
Rok: 2014
Stránky: 468 p. 56 illus., 52 illus. in color.
ISBN: 978-3-7091-1431-5
Nakladatelství: Grada
Rok: 2014
Stránky: 616, DVD
ISBN: 859-404-924-027-2
Nakladatelství: Grada
Rok: 2014
Stránky: 904
ISBN: 978-80-247-4284-7
Nakladatelství: Grada
Rok: 2014
Stránky: 232
ISBN: 978-80-247-4787-3
Nakladatelství: Grada
Rok: 2014
Stránky: 208
ISBN: 978-80-247-4838-2
Nakladatelství: Grada
Rok: 2014
Stránky: 256
ISBN: 978-80-247-4532-9
Nakladatelství: Mladá fronta - Medical services
Rok: 2014
Stránky: 183
ISBN: 978-80-204-3236-0
Nakladatelství: Maxdorf
Rok: 2014
Stránky: 142
ISBN: 978-80-7345-390-9
Nakladatelství: Maxdorf
Rok: 2014
Stránky: 208
ISBN: 978-80-7345-389-3
Nakladatelství: Mladá fronta
Rok: 2014
Stránky: 112
ISBN: 978-80-204-3414-2
Nakladatelství: Current Media s.r.o.
Rok: 2014
Stránky: 146
ISBN: 978-80-260-6359-9
Nakladatelství: Grada
Rok: 2014
Stránky: 216
ISBN: 978-80-247-4650-0
Nakladatelství: MOÚ
Rok: 2014
Stránky: 353
ISBN: 978-80-86793-34-4
Nakladatelství: Grifart spol. s r.o.
Rok: 2014
Stránky: 288
ISBN: 978-80-905337-4-5
Nakladatelství: Maxdorf
Rok: 2013
Stránky: 88
ISBN: 9788073452933